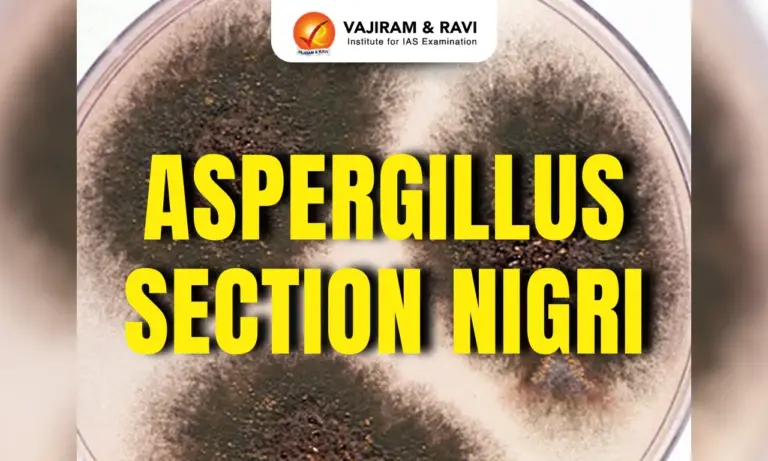
Aspergillus Section Nigri

Aspergillus Section Nigri Latest News
Agharkar Research Institute in Pune, an autonomous institute of the Department of Science & Technology, recently identified two novel species of Aspergillus section Nigri (commonly known as black aspergillus), Aspergillus dhakephalkarii and Aspergillus patriciawiltshireae.
About Aspergillus Section Nigri
- Aspergillus section Nigri comprises filamentous fungi.
- It is a taxonomic group within the genus Aspergillus, characterized by its black-pigmented conidia (spores) and diverse metabolic capabilities.
- Their colonies usually appear black due to pigmented conidia.
- This section includes species that are significant in food spoilage, industrial applications, and human health, particularly in relation to mycotoxin production and opportunistic infections.
- While primarily sourced from soil, certain members of this group have been observed in various environments such as decaying organic material and on the surfaces of plants, contributing to food spoilage and diseases in maize, onions, grapes, and peanuts.
- Strains of Aspergillus section Nigri can colonize maize and small grains (which include wheat, triticale, spelt, etc.) during pre-harvest, harvest, or post-harvest storage phases.
- Their ability to colonize diverse substrates underscores the importance of understanding their taxonomy, ecology, and potential impacts on agricultural, and food safety.
- Some strains of Aspergillus niger are known to secrete ochratoxins –mycotoxins which can give rise to nephrotoxicity and renal tumours in a variety of animal species and are potentially hazardous to human health through their consumption.
- A. niger is one of the most widely used fungi in biotechnology.
- Production of citric acid, gluconic acid, and various enzymes (amylases, proteases, and cellulases).
- Used in food processing, pharmaceuticals, and bioengineering.
Source: DDN
Last updated on March, 2026
→ UPSC Final Result 2025 is now out.
→ UPSC has released UPSC Toppers List 2025 with the Civil Services final result on its official website.
→ Anuj Agnihotri secured AIR 1 in the UPSC Civil Services Examination 2025.
→ UPSC Marksheet 2025 is now out.
→ UPSC Notification 2026 & UPSC IFoS Notification 2026 is now out on the official website at upsconline.nic.in.
→ UPSC Calendar 2026 has been released.
→ Check out the latest UPSC Syllabus 2026 here.
→ UPSC Prelims 2026 will be conducted on 24th May, 2026 & UPSC Mains 2026 will be conducted on 21st August 2026.
→ The UPSC Selection Process is of 3 stages-Prelims, Mains and Interview.
→ Prepare effectively with Vajiram & Ravi’s UPSC Prelims Test Series 2026 featuring full-length mock tests, detailed solutions, and performance analysis.
→ Enroll in Vajiram & Ravi’s UPSC Mains Test Series 2026 for structured answer writing practice, expert evaluation, and exam-oriented feedback.
→ Join Vajiram & Ravi’s Best UPSC Mentorship Program for personalized guidance, strategy planning, and one-to-one support from experienced mentors.
→ Shakti Dubey secures AIR 1 in UPSC CSE Exam 2024.
→ Also check Best UPSC Coaching in India
Aspergillus Section Nigri FAQs
Q1. What is Aspergillus section Nigri?+
Q2. Why the colonies of fungi belonging to Aspergillus section Nigri appear black?+
Q3. What is the primary ecological source of Aspergillus section Nigri fungi?+
Tags: prelims pointers upsc current affairs upsc prelims current affairs